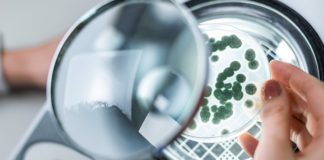
Manejo biológico da semente à colheita eleva a sustentabilidade e a ecoefiência da produção

GestAgro 360° é um portal que fala diretamente com
o produtor rural, levando informações que contribuem para ampliar a produtividade da propriedade agropecuária e a qualidade da produção. Para isso, genética, cultivares, defensivos e fertilizantes - químicos, orgânicos e biológicos - nutrição animal, tecnologia em máquinas, equipamentos e implementos, assim como eventos, pesquisas, desenvolvimentos e inovações que melhoram e facilitam o dia a dia do agropecuarista são assuntos presentes neste espaço, sempre tendo o objetivo de fazer um giro pelo universo da agropecuária brasileira.
GestAgro 360º é uma iniciativa da VetorCom e da jornalista Katia Penteado.
Contato: contato@gestagro360.com.br
© GestAgro -Todos os direitos reservados - Desenvolvido pela Absoluta Brasil